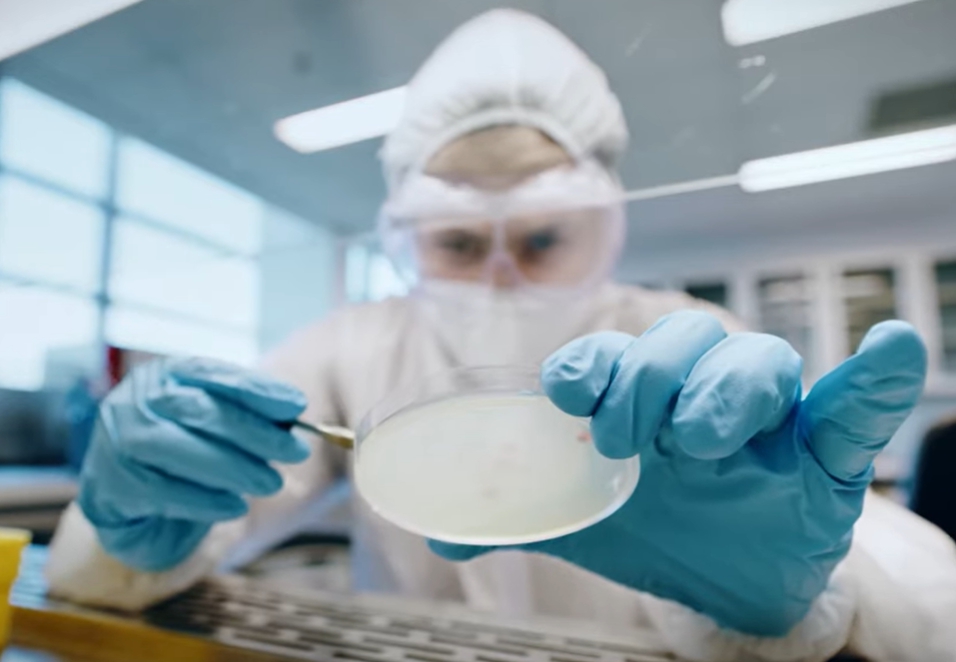
라이신 효능

1. 서론 | 우리 몸에 꼭 필요한 필수 아미노산, 라이신
라이신 효능은 건강 정보를 찾는 사람들이 꾸준히 검색하는 주제입니다. 라이신은 단백질을 구성하는 필수 아미노산 중 하나로, 우리 몸에서 스스로 만들 수 없어 반드시 음식이나 영양제를 통해 섭취해야 합니다. 특히 성장기 어린이, 면역력이 떨어진 성인, 피로가 잦은 사람에게 중요한 영양소로 알려져 있습니다.
라이신은 단순히 단백질 합성에만 관여하는 것이 아니라 면역 기능 유지, 콜라겐 생성, 피로 해소, 바이러스 억제 등 다양한 생리 작용에 관여합니다. 그래서 건강기능식품이나 종합 영양제 성분표에서도 라이신을 자주 볼 수 있습니다. 실제로 적절한 라이신 섭취는 일상적인 피로 관리와 신체 회복에 도움을 줄 수 있습니다.









2. 본론 | 과학적으로 알려진 라이신 효능
2-1. 면역 기능 유지와 바이러스 억제 도움
라이신 효능 중 가장 잘 알려진 것은 면역 기능과 바이러스 억제 작용입니다. 특히 입 주변에 반복적으로 발생하는 헤르페스 바이러스 활동을 억제하는 데 도움이 될 수 있다는 연구들이 알려져 있습니다.
라이신은 바이러스 증식에 필요한 특정 아미노산의 작용을 일부 억제하는 방식으로 작용할 수 있으며, 이 때문에 일부 의료 현장에서는 재발성 구순 포진 관리 보조 영양소로 언급되기도 합니다. 다만 치료제는 아니기 때문에 증상이 심한 경우에는 반드시 의료진 상담이 필요합니다.
2-2. 콜라겐 생성과 피부·관절 건강
라이신은 콜라겐 합성 과정에 중요한 역할을 합니다. 콜라겐은 피부, 뼈, 힘줄, 연골을 구성하는 주요 단백질이기 때문에 라이신이 부족하면 조직 회복 속도가 느려질 수 있습니다. 특히 다음과 같은 경우 라이신 섭취가 도움이 될 수 있습니다.
- 피부 탄력 유지
- 상처 회복 과정 지원
- 관절과 연골 건강 유지
따라서 단백질 섭취가 부족하거나 피부 회복이 느린 사람에게는 라이신이 중요한 영양소가 될 수 있습니다.
2-3. 칼슘 흡수와 뼈 건강 지원
잘 알려지지 않았지만 라이신 효능 중 하나는 칼슘 흡수 촉진입니다. 라이신은 장에서 칼슘 흡수를 돕고 체내에서 칼슘이 빠져나가는 것을 줄이는 데 관여할 수 있습니다. 이 때문에 다음과 같은 상황에서 라이신이 도움 될 수 있습니다.
- 성장기 어린이의 뼈 성장
- 골밀도 관리가 필요한 중장년층
- 칼슘 섭취는 충분하지만 흡수가 걱정되는 경우
즉 라이신은 단순한 아미노산이 아니라 뼈 건강에도 간접적인 역할을 하는 영양소입니다.
2-4. 피로 회복과 근육 회복 지원
라이신은 단백질 합성과 근육 회복 과정에도 중요한 역할을 합니다. 운동 후 근육 회복이나 체력 관리에 단백질이 중요한 이유도 바로 이런 아미노산 때문입니다. 특히 다음과 같은 경우 라이신의 역할이 중요합니다.
- 운동 후 근육 회복
- 만성 피로 상태
- 단백질 섭취가 부족한 식단
균형 잡힌 단백질 섭취와 함께 라이신이 충분히 공급되면 신체 회복 속도를 유지하는 데 도움이 될 수 있습니다.









3. 결론 | 라이신은 작지만 중요한 건강 영양소
정리하면 라이신 효능은 단순한 영양 보충을 넘어 면역 기능, 콜라겐 생성, 뼈 건강, 근육 회복 등 다양한 신체 기능과 관련되어 있습니다. 특히 우리 몸에서 스스로 합성되지 않는 필수 아미노산이기 때문에 식단을 통해 꾸준히 섭취하는 것이 중요합니다.
라이신은 육류, 생선, 달걀, 콩류, 유제품 등에 비교적 풍부하게 들어 있습니다. 평소 단백질 섭취가 부족하거나 피로가 잦은 경우라면 식단을 점검해 보는 것도 도움이 됩니다. 다만 특정 영양소만 과도하게 섭취하기보다는 균형 잡힌 식단과 생활습관을 함께 관리하는 것이 가장 건강한 방법입니다.

'생활 정보 및 뉴스' 카테고리의 다른 글
| 쫓기는 꿈해몽 / 도망가는 꿈해몽 / 탈출하는 꿈해몽 / 숨어있는 꿈해몽 (0) | 2026.03.10 |
|---|---|
| 가족이 죽는 꿈해몽 / 자식이 죽는 꿈해몽 / 사람이 죽는 꿈 / 내가 죽는 꿈해몽 / (0) | 2026.03.09 |
| 친구랑 싸우는 꿈해몽 / 말싸움 꿈해몽 / 말싸움 이기는 꿈 / 가족과 싸우는 꿈 (0) | 2026.03.08 |
| 이빨 왕창 빠지는 꿈 / 이빨 깨지는 꿈 / 이빨 흔들리는 꿈 / 이빨 빠지는 꿈 (0) | 2026.03.07 |
| 노니 효능 부작용 (0) | 2026.03.05 |